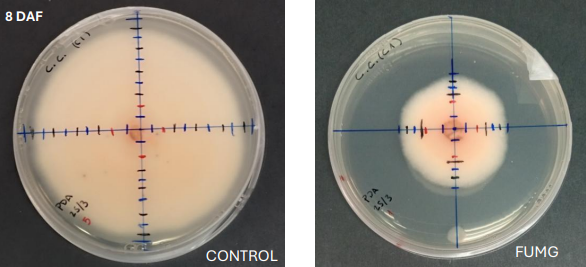

GO NATURSMOKE has continued developing new smoke products.

During this year's project, GO NATURSMOKE has continued to advance the development of the fumigant products under development, with promising results in both product formulation and burn behavior. In addition, in vitro efficacy trials have been conducted against some of the main pathogens responsible for the greatest losses in berry crops: Colletotrichum acutatum, Botrytis cinerea, Phytophthora cactorum and Fusarium oxysporum.
Specifically, these tests were conducted under two different application regimens. The preventive regimen consisted of applying the fumigant before infection occurred or visible symptoms appeared, with the goal of preventing the pathogen from establishing itself in plant tissues. The curative regimen, on the other hand, was based on applying the product once it had begun, seeking to halt the development of the pathogen, slow its spread, and minimize damage to the plant.
In parallel with this work, the residuality of the product on the key material has been studied. This analysis is key to determining agronomic safety parameters such as re-entry time and safety period. All in all, this work has led to progress toward effective and safe solutions for phytosanitary protection in crops, contributing to more sustainable and technologically advanced production.

«Content responsible: OPERATIVE GROUP NATURSMOKE»
